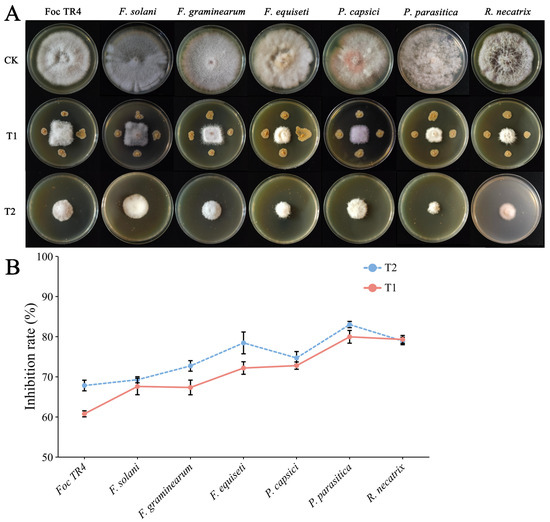

Abstract
Streptomycetes are vital microbial resources used in agriculture and biotechnology and are diverse secondary metabolites. The Streptomyces olivoreticuli YNK-FS0020 strain was isolated from the rhizosphere soil in Yunnan’s Wuliangshan Forest; its functions were explored via a series of experiments and genomic analysis. Indoor assays showed that this strain inhibits seven plant pathogens (including Fusarium oxysporum f. sp. cubense Tropical Race 4) and exhibits phosphorus solubilization, siderophore production, and plant-growth promotion. Genomic analysis revealed 47 secondary metabolite biosynthetic gene clusters: 12 shared over 60% similarity with known clusters (4 exhibited 100% similarity, involving antimycin and ectoine), while 19 showed low similarity or unknown functions, indicating the strain’s potential in the development of novel compounds. Genes related to tryptophan-IAA synthesis, phosphate metabolism, and siderophore systems were annotated, while metabolomics detected indole-3-acetic acid and kitasamycin, revealing mechanisms like hormonal regulation and antimicrobial secretion. In summary, YNK-FS0020 has potential for use in plant-growth promotion and disease control, aiding agricultural microbial resource utilization.
1. Introduction
Soil-borne diseases, caused by soil-borne pathogens, pose a significant threat to global crop production and can result in substantial economic losses [1]. Due to the complexity of pathogenic agents, controlling soil-borne pathogens is an arduous task. These pathogens can persist in soil or plant residues for extended periods of time and can infect a wide range of hosts [2], leading to symptoms such as root rot, stunted growth, and seedling wilting in host plants. This complicates the management of crop diseases, thereby causing significant reductions in the yield and quality of important cash crops [3]. Chemical control has been the primary method for preventing these diseases. However, the improper use of chemical products can cause a series of problems, including crop residues, soil contamination, ecological imbalance, and the development of pathogen resistance [4,5]. In recent years, the concepts of ecology and sustainable development have been accepted worldwide, and biological control methods and agents have attracted increasing attention in the integrated management of soil-borne diseases [6,7]. The application of biological control agents helps combat multiple pathogens in different crops, promote plant growth, induce plant defense against pathogen attacks, and improve and maintain soil productivity [8,9].
Actinomycetes are Gram-positive bacteria with significant biosynthetic potential, capable of producing a variety of bioactive secondary metabolites [10]. The genus Streptomyces, the largest of the Actinomycetes, comprises over 500 species [11]. Ubiquitous in soil environments, they hold enormous agricultural application potential [12]. Streptomyces can synthesize diverse secondary metabolites with broad bioactivities which bring substantial benefits to plant growth and disease resistance. They produce a wide range of metabolites, such as alkaloids, terpenoids, as well as macrolides, cyclic peptides, and polyketides. Among these, antibiotics are the most prominent secondary metabolites [13,14]. Exposure to these antibiotics can hinder the biosynthesis of cell wall components [15,16], alter cell membrane permeability [17], and inhibit the activity of ribosomes, RNA, or enzymes in harmful microorganisms [18,19], thereby achieving the effect of antagonizing pathogenic microbes. Additionally, studies have shown that Streptomyces isolates have the potential to promote plant growth by producing indole-3-acetic acid (IAA) [20].
Whole-genome sequencing provides a foundation for comprehensively understanding the technical characteristics and safety of bacterial strains at the genetic level by generating detailed genomic data. It facilitates in-depth exploration of the antagonistic mechanisms of biocontrol strains and provides valuable information for their application. One strain of Streptomyces olivoreticuli YNK-FS0020 was isolated from the rhizosphere soil of Wuliangshan Forest in Dali, Yunnan Province, China. Whole-genome sequencing of YNK-FS0020 was performed using the Illumina HiSeq high-throughput sequencing platform, followed by gene prediction, functional annotation, and the prediction of secondary metabolite biosynthetic gene clusters. Combined with non-targeted metabolomics, this study aims to identify genes and metabolites related to plant-growth promotion and pathogen antagonistic activity, reveal the biocontrol mechanisms, and provide a theoretical basis for the application of S. olivoreticuli YNK-FS0020 in plant-growth promotion and the biological control of plant diseases.
2. Materials and Methods
2.1. Materials and Culture Media
The YNK-FS0020 strain was isolated from the rhizosphere soil of Wuliangshan Forest in Dali, Yunnan Province. The indicator pathogens involved in this study, i.e., Fusarium oxysporum f. sp. cubense Tropical Race 4 (TR4), Fusarium solani, Fusarium graminearum, Fusarium equiseti, Phytophthora capsici, Phytophthora parasitica, and Rosellinia necatrix, were provided by the Institute of Agricultural Environment and Resources, Yunnan Academy of Agricultural Sciences. The culture media used were Gause’s No. 1 liquid medium (composed of 20.0 g soluble starch, 1.0 g KNO3, 1.0 g KH2PO4, 0.5 g MgSO4·7H2O, 0.5 g NaCl, 0.5 g FeSO4·7H2O, dissolved in 1000 mL distilled water, with pH adjusted to 7.2 ± 0.2) and potato dextrose agar (PDA) liquid medium (composed of 200.0 g peeled potatoes, 20.0 g glucose, and 1000 mL distilled water, with pH adjusted to 5.6 ± 0.2). The solid formulations of the aforementioned media were prepared by adding 18–20 g agar to 1000 mL liquid basal medium.
2.2. Physiological and Biochemical Tests of Strain YNK-FS0020
A series of physiological and biochemical characterization tests was performed on the YNK-FS0020 strain, i.e., Gram staining, the citrate utilization test, fructose, lactose, mannitol and inositol utilization tests, the methyl red test, the Voges–Proskauer (V-P) test, the gelatin liquefaction test, the hydrogen sulfide (H2S) production test, the starch hydrolysis test, and the cellulose hydrolysis test [21]. Each physiological and biochemical test was conducted with three replicates.
2.3. Scanning Electron Microscopy Sample Preparation and Morphological Observation of Strain YNK-FS0020
The strain was inoculated into Gauze’s No. 1 liquid medium and cultured at 28 °C with shaking at 180 rpm for 48 h; the fermentation broth was then harvested, and bacterial cells were collected by centrifugation at 10,000 rpm and 4 °C for 10 min, followed by three washes with 0.1 mol/L phosphate-buffered saline (PBS, pH 7.2) before being fixed in 2.5% glutaraldehyde solution at 4 °C for 4 h. After rinsing with the same PBS, the cells were subjected to gradient dehydration using 30%, 50%, 70%, 90%, and 100% ethanol (15 min per concentration), dried, and coated with a 10–20 nm gold film. Finally, the surface morphological characteristics of the bacterial cells were observed and recorded using a scanning electron microscope at an accelerating voltage of 5 kV [22].
2.4. Antagonism Test of Strain YNK-FS0020 Against Pathogenic Fungi
Dual culture assay: The mycelia of pathogens were picked with an inoculating loop and cultured on PDA medium for 5 days. A 5-mm pathogenic cake was punched from the edge of the pathogenic colony using a puncher and placed at the center of a new PDA medium. The functional strains were inoculated at 25 mm away from the pathogenic cake in a cross shape. Plates without inoculation served as controls, with three replicates for each strain. All plates were incubated in a constant temperature incubator at 28 °C in the dark for 5–7 days. The colony diameters of pathogens were measured using the cross method, and the inhibition rates were calculated. Inhibition rate (%) = ((colony diameter of control group − colony diameter of treatment group)/(colony diameter of control group − 5 mm)) × 100.
Antimicrobial test with non-volatile substances: A single colony of strain YNK-FS0020 was picked and inoculated into PDA liquid medium, then cultured at 28 °C at 180 rpm for 48 h to prepare the fermentation broth. The fermentation broth was diluted to an OD600 of 1.0 and centrifuged at 10,000 rpm for 15 min at room temperature, and the supernatant was filtered through a 0.22 μm filter membrane to remove bacterial cells. Then, 200 mL of sterilized PDA solid medium was heated to melt and cooled to approximately 50 °C, and then 20 mL of the filtered fermentation supernatant was added, mixed thoroughly, and poured into plates. After the plates had solidified, pathogenic cakes were inoculated. PDA plates without added fermentation supernatant were used as controls, with three replicates for each treatment. After incubation at 28 °C for 5–7 days, the colony growth diameter was measured, and the inhibition rate was calculated [23]. Inhibition rate (%) = ((colony diameter of control group − colony diameter of treatment group)/(colony diameter of control group − 5 mm)) × 100.
2.5. PGP Bioactivity Assays of Strain YNK-FS0020
The nitrogen-fixing ability of the strain was determined using Ashby nitrogen-free solid medium (10 g glucose, 0.2 g K2HPO4, 0.2 g NaCl, 0.2 g MgSO4·H2O, 0.2 g K2SO4, 5 g CaCO3, 18 ± 2 g agar, 1000 mL distilled water) [24]. Strain YNK-FS0020 was inoculated onto this medium and cultured in a constant temperature incubator at 28 °C for 5–7 days. Its nitrogen-fixing ability was evaluated by observing the growth status of the strain and the formation of transparent zones around the colonies. The phosphate-solubilizing potential of YNK-FS0020 was qualitatively assessed using inorganic phosphorus solid medium [25]. The siderophore-producing ability of the strain was determined using CAS (Chrome Azurol S) solid detection medium [26]. After inoculation, the plates were incubated in a constant temperature incubator at 28 °C for 5–7 days, during which the bacterial growth and the formation of orange halos around the colonies were observed daily.
2.6. Determination of Growth-Promoting Effect of Strain YNK-FS0020 on Greenhouse Tomato Seedlings
Strain YNK-FS0020 was preserved at −80 °C. For the experiment, a bacterial loop was used to dip the bacterial suspension, and streak inoculation was performed on a newly prepared Gause’s No. 1 solid medium plate, followed by incubation at 28 °C until colonies emerged. A single colony of YNK-FS0020 was picked with a bacterial loop and inoculated into 100 mL Gause’s No. 1 liquid medium, then cultured with shaking at 28 °C at 180 rpm for 48 h to obtain the bacterial fermentation broth (with a viable count of approximately 1 × 109 CFU/mL). Using sterile water irrigation (CK1) and Gause’s No. 1 liquid medium (CK2) as controls, three treatments were set up: bacterial fermentation broth (T1), 10-fold diluted bacterial fermentation broth (T2, with a viable count of approximately 1 × 108 CFU/mL), and 100-fold diluted bacterial fermentation broth (T3, with a viable count of approximately 1 × 107 CFU/mL).
Root irrigation treatment was applied to tomato seedlings on the 8th day after they had been transplanted into flowerpots, with 200 mL per pot. Each treatment was set with four pots of plants as biological replicates (one seedling per pot), and the experiment was independently repeated three times. After root irrigation, the tomato seedlings were placed in a greenhouse (temperature 25 °C, 16 h light/8 h dark) for growth, with sufficient soil moisture maintained during the period. Thirty days after root irrigation, the plant height, root length, stem diameter, aboveground fresh weight, and underground fresh weight were measured.
Statistical analysis was performed using SPSS 26.0 software. First, one-way analysis of variance (One-way ANOVA) was used to test the significance of differences among different treatment groups. If the ANOVA results indicated significant differences (p < 0.05), further pairwise comparisons between groups were conducted using the Duncan’s multiple range test, with the significance level set at p < 0.05. By analyzing the differences in various growth indicators (plant height, root length, stem diameter, aboveground fresh weight, and underground fresh weight) between different treatment groups and control groups, the growth-promoting effect of strain YNK-FS0020 on tomato seedlings and its concentration dependence were clarified.
2.7. Genome Sequencing, Annotation, and Analysis of Strain YNK-FS0020
Strain YNK-FS0020 was inoculated into Gause’s No. 1 liquid medium and cultured at 28 °C with shaking at 180 r/min for 48 h. The bacterial cells were collected after centrifuging the culture at 10,000 rpm for 15 min. Genomic DNA of the strain was extracted using the QIAamp DNA Mini Kit, and the quality and quantity of DNA were detected with a Nanodrop 2500 spectrophotometer. High-quality DNA was then used for library construction, followed by Illumina HiSeq X Ten and PacBio RSII sequencing (Majorbio Bio-Pharm Technology, Shanghai, China). Bioinformatics analysis was performed using the Majorbio Cloud Platform. Coding sequences (CDS) in the genome were predicted using Glimmer v3.02, GeneMarkS v4.3, and Prodigal v2.6.3 software. TRNAs in the genome were predicted using tRNAscan-SE v2.0.12, and rRNAs were predicted using Barrnap v0.9 software. The predicted CDS were functionally annotated against the NR, GO, KEGG, COG, CAZY, CARD, Pfam, Swiss-Prot, and TCDB databases. Gene clusters involved in secondary metabolite biosynthesis were predicted using the online antiSMASH v7.1.0 database [27].
Comparative genomic analysis was performed using various software tools. BLAST Ring Image Generator v0.95 was used to visualize genomic comparisons among the five strains [28]. OrthoVenn 3 was employed for whole-genome orthologous gene comparison [29]. In this analysis, the coding sequences (CDS) of S. olivoreticuli YNK-FS0020, S. olivoreticuli ZZ-21, S. albireticuli MDJK11, S. griseus NBC-01630, and S. venezuelae ATCC-10712 were used. CDS related to YNK-FS0020 were analyzed via BLAST search with specific parameters (E-value < 1 × 10−5, minimum alignment length percentage > 40%) [30].
2.8. Non-Targeted Metabolomics Analysis of Metabolites from Strain YNK-FS0020
The fermentation broth of the strain was prepared using PDA liquid medium, and samples of the prepared fermentation filtrate (centrifuged at 10,000 rpm for 15 min, with the supernatant filtered through a 0.22 μm membrane) were sent to Tsingke Biological Technology (Beijing, China) for non-targeted metabolomics analysis. The testing conditions were as follows. Chromatographic conditions: an Agilent 1290 high-performance liquid chromatography system (Agilent Technology, Waldbronn, Germany) was used, equipped with an Agilent Zorbax RRHD C18 column (Agilent Technology, New Castle, DE, USA) (100 × 3.0 mm, 1.8 μm), with the column temperature set at 35 °C, an injection volume of 1 μL, mobile phases consisting of phase A (water containing 0.1% formic acid) and phase B (acetonitrile containing 0.1% formic acid); the gradient elution program: 5% B at 0 min, 60% B at 10 min, 95% B at 13 min, 95% B maintained until 15 min, with a post-run time of 3 min and a flow rate of 0.35 mL/min; and mass spectrometric conditions: an Agilent 6546 QTOF mass spectrometer (Agilent Technology, Santa Clara, CA, USA) was used with an electrospray ionization (ESI) source, operating in both positive (ESI+) and negative (ESI−) ion modes, with capillary voltages of 4 kV (ESI+) and 3.5 kV (ESI−), respectively, a drying gas temperature and flow rate of 300 °C and 10 L/min, respectively, and a sheath gas temperature and flow rate of 350 °C and 12 L/min, respectively. The obtained data were processed for peak detection, filtering, and alignment using MS Dial v4.92, and metabolite annotation was performed against databases such as Massbank, ultimately generating a list of qualitatively and quantitatively identified substances.
3. Results
3.1. Phenotypic Characteristics and Physiological-Biochemical Properties of Strain YNK-FS0020
Morphological observations revealed that colonies of strain YNK-FS0020 on Gause’s No. 1 solid medium appeared pale yellowish-white, with a slightly elevated center and regular margins (Figure 1A). The cells of YNK-FS0020 were filamentous, either straight or curved (Figure 1B). Physiological and biochemical characterization indicated that strain YNK-FS0020 tested positive for Gram staining, gelatin liquefaction, starch hydrolysis, and cellulose hydrolysis, but negative in the methyl red test and for the Voges-Proskauer reaction and hydrogen sulfide production. Additionally, YNK-FS0020 was able to utilize citrate, fructose, lactose, and inositol as carbon sources, but not mannitol (Table S1).

Figure 1.
Morphological identification of strain YNK-FS0020. (A) Colony morphology on Gause’s No. 1 solid medium; (B) Scanning electron microscopy image of strain YNK-FS0020.
3.2. Molecular Identification of Strain YNK-FS0020
The 16S rRNA gene is a highly conserved sequence and is frequently used for microbial identification and classification. Phylogenetic analysis based on the 16S rRNA gene sequence showed that strain YNK-FS0020 shared 99.93% sequence similarity with S. olivoreticuli ATCC-31159 [31] (Figure 2A). The phylogenetic tree constructed using 31 housekeeping genes (dnaG, frr, infC, nusA, pgk, pyrG, rplA, rplB, rplC, rplD, rplE, rplF, rplK, rplL, rplM, rplN, rplP, rplS, rplT, rpmA, rpoB, rpsB, rpsC, rpsE, rpsI, rpsJ, rpsK, rpsM, rpsS, smpB, and tsf) also revealed that strain YNK-FS0020 had the highest homology (98.80%) with S. olivoreticuli ATCC-31159 (Figure 2B). Analysis of average nucleotide identity (ANI) and digital DNA-DNA hybridization (dDDH) values among 12 Streptomyces strains indicated that strain YNK-FS0020 shared the highest ANI (97.35%, >95%) and dDDH (76.60%, >70%) values with S. olivoreticuli ZZ-21, followed by S. olivoreticuli ATCC-31159 (Table S2). Combined with its morphological, physiological, and biochemical characteristics, strain YNK-FS0020 was identified as S. olivoreticuli.

Figure 2.
Phylogenetic tree construction based on 16S rRNA (A) and 31 housekeeping genes (B).
3.3. Evaluation of Broad-Spectrum Antagonistic Activity of Strain YNK-FS0020
The results of the plate antagonism assay showed that strain YNK-FS0020 exhibited antagonistic activity against seven plant pathogens, namely, F. oxysporum f. sp. cubense TR4, F. solani, F. graminearum, F. equiseti, P. capsici, P. parasitica, and R. necatrix (Figure 3A). The results indicated that it had the highest inhibition rate on the mycelial growth of P. parasitica, reaching 79.92%, followed by R. necatrix, with an inhibition rate of 79.26%. The mycelial growth inhibition rates against F. oxysporum f. sp. cubense TR4, F. solani, F. graminearum, F. equiseti, and P. capsici were 60.73%, 67.56%, 67.30%, 72.14%, and 72.74%, respectively (Figure 3B).
Figure 3.
Antagonistic effect of strain YNK-FS0020 against pathogens. (A) Images of the antagonistic activity of strain YNK-FS0020 against various pathogens; (B) Inhibition rates of strain YNK-FS0020 against various pathogens. CK: Control group (pathogens cultured alone); T1: Plate confrontation assay group; T2: Non-volatile substances treatment group.
The assay for antimicrobial activity of non-volatile substances showed that compared with the control group, the growth of the pathogens on the plates supplemented with fermentation supernatant was significantly inhibited (Figure 3A). Strain YNK-FS0020 had the strongest inhibitory effect on P. parasitica (82.97%), followed by R. necatrix (78.88%). It also exhibited obvious inhibitory effects on F. oxysporum f. sp. cubense TR4, F. solani, F. graminearum, F. equiseti, and P. capsici, with inhibition rates of 67.78%, 69.22%, 72.67%, 78.40%, and 74.66%, respectively (Figure 3B). These results indicated that the fermentation broth of strain YNK-FS0020 contained certain antimicrobial substances that could inhibit the growth of the pathogens.
3.4. Evaluation of PGP Bioactivity and Plant Growth-Promoting Effect of Strain YNK-FS0020
Qualitative tests for Plant Growth-Promoting (PGP) bioactivity in this study revealed that strain YNK-FS0020 exhibited the capabilities of solubilizing inorganic (Figure 4B) and organic phosphorus (Figure 4C) and producing siderophores (Figure 4D); however, it lacked nitrogen-fixing ability (Figure 4A). Greenhouse pot experiments showed that strain YNK-FS0020 could significantly promote the growth of tomato plants. Compared with the treatment irrigated with sterile water, the tomato plants irrigated with the undiluted fermentation broth of strain YNK-FS0020 showed significant increases in plant height (20.08%), root length (51.78%), stem diameter (18.72%), aboveground fresh weight (63.65%), and underground fresh weight (80.48%) (Figure 4E,F). In addition, the agronomic traits of plants treated with 10-fold and 100-fold diluted fermentation broth were also significantly improved compared with those treated with sterile water. These results indicated that strain YNK-FS0020 has a good ability to promote plant growth and has the potential to be further developed as a plant growth-promoting agent.

Figure 4.
PGP bioactivity of strain YNK-FS0020 and its promoting effect on plant growth. (A) Nitrogen fixation; (B) Inorganic phosphorus solubilization; (C) Organic phosphorus solubilization; (D) Siderophore production; (E) Photographs of tomato plants 30 days after inoculation with YNK-FS0020; (F) Agronomic traits of tomato plants measured 30 days after inoculation with YNK-FS0020. Different letters indicate significant differences among treatments (Duncan’s test, p < 0.05). CK1: Sterile water treatment; CK2: Gause’s No. 1 liquid medium treatment; T1: Fermentation broth of strain YNK-FS0020; T2: 10-fold diluted fermentation broth of strain YNK-FS0020; T3: 100-fold diluted fermentation broth of strain YNK-FS0020.
3.5. Genome Sequencing and Analysis of Strain YNK-FS0020
The whole genome of strain YNK-FS0020 was sequenced using a combined sequencing technology of the second-generation BGISEQ platform and the third-generation PacBio platform. The results showed that strain YNK-FS0020 consists of two circular chromosomes with lengths of 6,529,062 bp and 1,547,401 bp, respectively, and one plasmid with a length of 49,706 bp (Figure 5). Its GC content is 71.42%, encoding a total of 7105 genes with a gene coding rate of 88.09%. The longest sequence length is 28,503 bp, the shortest is 90 bp, and the average length of the coding genes is 1007.50 bp. There are 73 tRNA genes, belonging to 20 types in total, 21 rRNA genes, including 7 16S rRNA, 7 23S rRNA, and 7 5S rRNA genes, 31 housekeeping genes, and 86 sRNA genes with a total sequence length of 9629 bp, ranging in size from 49 to 403 bp, accounting for 0.1185% of the total genome length. There are 201 tandem repeat sequences with a total length of 40,207 bp, ranging in size from 40 to 1807 bp, accounting for 0.56% of the total genome length. Four prophages were identified in the prophage prediction, with a total sequence length of 40,732 bp; 16 genomic islands were found in the genomic island analysis. The transmembrane protein prediction results showed that 1479 protein-coding genes in the chromosomal sequences contain at least one or more transmembrane helix regions. The secreted protein prediction results indicated that 182 protein-coding genes in the chromosomal sequences contain secreted protein sequences. The genome sequencing data of strain YNK-FS0020 have been submitted to GenBank with the accession number JBMYHM000000000 (Table 1).

Figure 5.
The genome circle of S. olivoreticuli YNK-FS0020 strain. Note: From the inside to the outside, the first circle represents the scale, the second lap represents GC Skew, the third circle represents the GC content, the fourth and seventh circles represent the COG to which each CDS belongs, and the fifth and sixth circles represent the position of CDS, tRNA, and RNA on the genome.

Table 1.
Genomic features of strain YNK-FS0020.
3.6. Comparative Genomic Analysis of Strain YNK-FS0020
To perform comparative genomic analyses of the chromosomal genome of S. olivoreticuli YNK-FS0020 with other representative Streptomyces strains, the complete genome sequences from the NCBI sequence database (ZZ-21, MDJK11, NBC-01630, and ATCC-10712) were analyzed using BRIG v0.95 software. The results showed that in terms of genomic structure and sequence identity, strain YNK-FS0020 has the highest whole-genome sequence similarity with S. olivoreticuli ZZ-21, with fewer gene variations or deletions compared to other strains (Figure 6A,D, Table S3).

Figure 6.
Comparative genomic analysis of S. olivoreticuli YNK-FS0020 chromosome with S. olivoreticuli ZZ-21, S. albireticuli MDJK11, S. griseus NBC-01630 and S. venezuelae ATCC-10712. (A,D): the comparative genomic circle map was constructed using BRIG v0.95. The features are as follows (from center to outside): circle 1 is genome size, circle 2 is GC Content, circle 3 is GC Skew, and circles 4–8 are the comparative genomic maps of S. olivoreticuli YNK-FS0020, S. olivoreticuli ZZ-21, S. albireticuli MDJK11, S. griseus NBC-01630, and S. venezuelae ATCC-10712, respectively; the outermost circle indicates the positions of gene clusters of predicted secondary metabolites. (B,E): Venn diagram showing the number of unique, accessory, and core genes shared in different species. The core and accessory genes are those located at the intersection of the five circles. The number of unique genes of each species is shown in each corresponding circle. The middle bar chart represents the total number of genes harbored by each individual strain. The bottommost figure shows the number of genes shared by 1, 2, 3, 4, and 5 strains, respectively. Annotation was performed using OrthoVenn3. (C,F): Presence or absence of orthologous gene clusters in different species. Dark green indicates presence, light green indicates absence.
In addition, pan-genomic analysis of the whole genome was conducted by comparing S. olivoreticuli YNK-FS0020 with S. olivoreticuli ZZ-21, S. albireticuli MDJK11, S. griseus NBC-01630, and S. venezuelae ATCC-10712. The results indicated that Chromosome 1 of S. olivoreticuli YNK-FS0020 shares 2835 homologous genes with the four comparison strains and contains 22 unique homologous gene clusters, encoding a total of 46 proteins (Figure 6B,C). Chromosome 2 of S. olivoreticuli YNK-FS0020 shares 418 homologous genes with the four comparison strains and contains 2 unique homologous gene clusters, encoding a total of 4 proteins (Figure 6E,F).
3.7. Genome Annotation Results of Strain YNK-FS0020
The protein sequences of the predicted genes were aligned against functional databases (NR, GO, KEGG, COG, CAZy, CARD, Pfam, Swiss-Prot, and TCDB) using Diamond (E value ≤ 1 × 10−5). The alignment results with the highest scores (default identity ≥ 40% and coverage ≥ 40%) were selected for annotation. The final annotation statistics are shown in Figure 7. A large number of genes were functionally annotated in the NR, Pfam, COG, KEGG, Swiss-Prot, and GO databases, with 7018, 5600, 5216, 4578, 4569, and 1381 genes, accounting for 98.78%, 78.82%, 73.41%, 64.43%, 64.31%, and 19.44% of the total genes, respectively. A total of 506 genes were annotated in the CARD database, accounting for 7.12%, and 973 genes were annotated in the TCDB database, accounting for 13.69%. The fewest genes were annotated in the CAZy database, with 233 genes, accounting for 3.28% of the total genes.

Figure 7.
Gene functional annotation databases distribution of YNK-FS0020.
3.7.1. Results of Gene Analysis in COG Database for Strain YNK-FS0020
A total of 5216 genes from the whole-genome sequencing results of strain YNK-FS0020 were annotated using the COG database, accounting for 73.41% of all annotated genes. The results were classified into 4 major categories and 24 subcategories through multi-level classification (Figure 8). It should be noted that some genes were annotated into multiple categories. Among the 4 major categories, 2680 genes (44.78%) were classified into the metabolism category, 1458 genes (24.36%) into the cellular processes and signaling category, 1161 genes (19.40%) into the information storage and processing category, and 686 genes (11.46%) with unclear annotation characteristics. These results indicate that strain YNK-FS0020 is metabolically active, capable of providing substances, energy, and metabolic products for the bacterium. Among the 24 subcategories, the annotation results for transcription were the most abundant, with 732 genes (12.23), followed by general function prediction (544, 9.09%), amino acid transport and metabolism (491, 8.20%), lipid transport and metabolism (454, 7.59%), signal transduction mechanisms (418, 6.98%), and carbohydrate transport and metabolism (417, 6.97%). This suggests that the strain has great potential in terms of functional expression, viability, and ability to compete for nutrients with other strains.

Figure 8.
Functional annotation results of COG database in the genome of YNK-FS0020.
3.7.2. Results of Gene Analysis in KEGG Database for Strain YNK-FS0020
A total of 4578 genes in the genome of strain YNK-FS0020 were annotated in the KEGG database, which were classified into 6 major categories and 44 subcategories (Figure 9). Considering that some genes were assigned to multiple categories, among the 6 major categories, “Metabolism” contained the largest number of genes, with 4236 genes, accounting for 75.74%. Among the 44 subcategories, excluding 1660 annotations related to “Global and overview maps”, the most abundant ones were “Amino acid metabolism” (427 genes, 7.63%), “Carbohydrate metabolism” (422 genes, 7.55%), and “Metabolism of cofactors and vitamins” (326 genes, 5.83%).

Figure 9.
Functional annotation results of KEGG database in the genome of YNK-FS0020.
3.7.3. Results of Gene Analysis in GO Database for Strain YNK-FS0020
The amino acid sequences of strain YNK-FS0020 were aligned with the GO database and subjected to statistical analysis to determine the distribution of functional genes in the strain. A total of 1381 genes were annotated in the GO database, which categorizes proteins into three aspects: biological processes, cellular components, and molecular functions (Figure 10). There are 277, 35, and 416 branches in the biological process, cellular component, and molecular function categories, respectively, totaling 728 branches. In the biological process category, 625 genes were annotated, with the largest number of genes involved in the regulation of DNA-templated transcription, translation, and protein hydrolysis, accounting for 65, 44, and 40 genes, respectively. In the cellular component category, 486 genes were annotated, among which the genes related to membrane, cytoplasm, and plasma membrane showed the highest correlation, with 237, 101, and 82 genes, respectively. In the molecular function category, 1166 genes were annotated, with the most abundant genes involved in DNA binding, ATP binding, and metal ion binding, totaling 217, 110, and 84 genes, respectively.

Figure 10.
Functional annotation results of GO database in the genome of YNK-FS0020.
3.7.4. Results of Gene Analysis in CAZy Database for Strain YNK-FS0020
Alignment of the genome sequence with the CAZy database revealed that a total of 233 genes in the genome of strain YNK-FS0020 encode proteins with domains belonging to the CAZy family (Figure 11). These include 69 proteins from 40 glycoside hydrolase (GHs) families, 62 proteins from 14 glycosyltransferase (GTs) families, 74 proteins from 8 carbohydrate esterase (CEs) families, 18 proteins from 8 auxiliary activity (AAs) families, 8 proteins from 3 carbohydrate-binding module (CBMs) families, and 2 proteins from polysaccharide lyase (PLs) families. Among them, families related to chitin degradation, starch hydrolysis, and cellulose degradation were identified, including GH3, GH15, GH18, and GH39. Additionally, numerous genes were found in the genome of strain YNK-FS0020, which are involved in encoding endo-beta-1,4-glucanase and beta-glucosidase. These enzymes can decompose and utilize plant disease residues composed of sugars and proteins in the soil.

Figure 11.
Functional annotation results of CAZy database in the genome of YNK-FS0020.
3.7.5. Results of Gene Analysis in CARD Database for Strain YNK-FS0020
Alignment of the genome of strain YNK-FS0020 with the CARD database identified a total of 506 resistance genes, with specific drug classifications shown in Figure 12. Among these, resistance genes against macrolide antibiotics (88 genes, 10.13%), peptide antibiotics (81 genes, 9.32%), disinfecting agents and antiseptics (65 genes, 7.48%), and tetracycline antibiotics (65 genes, 7.48%) were more abundant. In terms of resistance mechanisms, there were 290 antibiotic efflux genes, 51 antibiotic inactivation genes, 164 antibiotic target genes (including antibiotic biosynthesis genes), and 1 gene related to reduced permeability to antibiotics.

Figure 12.
Functional annotation results of CARD database in the genome of YNK-FS0020.
3.8. Prediction and Analysis of Secondary Metabolite Biosynthetic Gene Clusters in Strain YNK-FS0020
Prediction using antiSMASH v7.1.0 software revealed 47 secondary metabolite biosynthetic gene clusters in the genome of strain YNK-FS0020 (Table 2). Only 4 of these gene clusters showed 100% similarity to those of known compounds, namely antimycin, antipain, geosmin, and ectoine, with their biosynthetic gene cluster diagrams shown in Figure S1. The remaining 43 gene clusters exhibited similarities lower than 85%, among which 5 gene clusters had no homologous known biosynthetic gene clusters identified. Relevant studies have indicated that biosynthetic gene clusters with similarities higher than 85% are likely to be identical to their most similar known gene clusters and belong to the same known compound, while those with similarity lower than 85% may produce novel metabolites. Therefore, strain YNK-FS0020 contains numerous novel active metabolites worthy of exploration [32,33].

Table 2.
Secondary metabolite biosynthetic gene clusters in strain YNK-FS0020 predicted by antiSMASH.
3.9. Analysis of PGP-Related Genes in Strain YNK-FS0020
Based on the annotation results from the KEGG database, genes related to IAA production, inorganic phosphorus solubilization, organic phosphorus mineralization, and siderophore production were further screened (Table 3). A complete set of tryptophan (a precursor of IAA) biosynthetic genes trpABCDEFS was identified in the genome of strain YNK-FS0020 (Figure S2), forming an intact biosynthetic pathway. Additionally, the amiE gene, which encodes amidase [EC:3.5.1.4] involved in the final step of the IAM pathway, was detected. This enzyme specifically hydrolyzes indole-3-acetamide (IAM) into IAA and ammonia, indicating that strain YNK-FS0020 has the potential to synthesize IAA without exogenous tryptophan supplementation.

Table 3.
Predicted PGP-related genes in the genome of strain YNK-FS0020.
The genome of YNK-FS0020 contains genes involved in phosphate transport and assimilation, such as pstB (ATP-binding protein), pstAC (permease protein), pstS (substrate-binding protein), phoU (phosphate transport system protein), and phoR (two-component system, OmpR family, phosphate regulon sensor histidine kinase PhoR). It also harbors ppa (inorganic pyrophosphatase) and phosphate metabolism regulatory genes ppx-gppA (exopolyphosphatase/guanosine-5′-triphosphate,3′-diphosphate pyrophosphatase). Furthermore, the YNK-FS0020 genome carries glpQ, a gene encoding glycerophosphodiester phosphodiesterase, which hydrolyzes glycerophosphodiesters into glycerol-3-phosphate and corresponding alcohols, participating in the catabolism of organic phosphorus compounds and converting organic phosphorus into inorganic forms utilizable by microorganisms. Genes related to pyrroloquinoline quinone (PQQ) synthesis, including pqqC, pqqD, pqqE, and pqqB, were also annotated. PQQ acts as a coenzyme for glucose dehydrogenase, which, in phosphorus-solubilizing microorganisms, collaborates with PQQ to catalyze the conversion of glucose to gluconic acid, thereby promoting the solubilization of insoluble inorganic phosphorus. Preliminary qualitative experiments also confirmed that strain YNK-FS0020 is capable of solubilizing both organic and inorganic phosphorus.
In addition, the genome of strain YNK-FS0020 contains a series of genes involved in iron uptake, transport, and siderophore biosynthesis. Among these, entABCEF are key genes in the enterobactin biosynthetic pathway; enterobactin is a potent iron chelator that efficiently binds environmental iron ions (especially Fe3+), enabling microorganisms to acquire iron nutrients in iron-deficient environments. fepCDG are responsible for transporting iron-bound enterobactin into cells. EfeUOB mediates Fe2+ uptake under microaerobic or anaerobic conditions and oxidizes it to Fe3+. afuA is involved in the uptake of various iron forms (e.g., free Fe3+ or other siderophore complexes). Preliminary experiments also confirmed the siderophore-producing ability of strain YNK-FS0020.
3.10. Non-Targeted Metabolomics Analysis of Strain YNK-FS0020
A non-targeted metabolomics approach was employed to detect and analyze the fermentation broth of strain YNK-FS0020, leading to the identification of 145 recognizable metabolites (Supplementary Excel S1) covering categories such as antibiotics and bacteriostatic substances, siderophores, amino acids and their derivatives, plant growth regulators, and antioxidant and antitumor active substances. Among them, antibiotic substances including kitasamycin [34], minocycline [35], and chloramphenicol [36] can exert bacteriostatic effects by inhibiting protein synthesis in pathogenic bacteria or interfering with their metabolism, facilitating the strain to gain an advantage in niche competition. Indole-3-acetic acid and its derivative (ethyl 3-indoleacetate) possess the function of regulating plant growth and may be involved in host-microbe interactions [37]. Siderophores such as deferrioxamine E [38] and ferrioxamine G1 [39] can enhance the strain’s nutrient acquisition ability by efficiently chelating iron ions in the environment, supporting its growth in iron-deficient environments. Hydroquinone [40] has antioxidant activity and can maintain cellular redox homeostasis by scavenging reactive oxygen species or chelating metal ions. Staurosporine [41], emodin [42], and mitomycin C [43] are known antitumor active substances, and their mechanisms of action may involve inhibiting tumor cell signaling pathways or inducing apoptosis. In summary, the versatility of the metabolites produced by strain YNK-FS0020 (in terms of ecological competition, nutrient utilization, biological activity regulation, etc.) indicates that it has strong comprehensive potential in environmental adaptation and biological resource development.
4. Discussion
Advances in genome sequencing and bioinformatics technologies have provided crucial support for microbial systematic classification and functional genomics research [44]. In this study, the taxonomic status of strain YNK-FS0020 was clarified, revealing its potential plant growth-promoting and biocontrol functions through whole-genome analysis. Phylogenetic trees constructed based on both 16S rRNA sequences and 31 housekeeping genes indicated that strain YNK-FS0020 is most closely related to S. olivoreticuli ATCC-31159. Further analysis of ANI and dDDH confirmed the taxonomic affiliation of strain YNK-FS0020, supporting its identification as S. olivoreticuli. A comparative genomic analysis revealed its unique genomic characteristics: the genome comprises two chromosomes (6.53 Mb and 1.55 Mb) and one plasmid (49.7 kb), with a total size of 8.13 Mb and 7105 coding genes. Both values are smaller than those of reference strains ZZ-21 (8.37 Mb, 7387 genes) and ATCC-31159 (8.81 Mb, 7520 genes). Notably, predictive analysis of secondary metabolite biosynthetic gene clusters (BGCs) showed that strain YNK-FS0020 contains 47 BGCs, significantly more than ZZ-21 (42) and ATCC-31159 (37). All three strains contain the ectoine biosynthetic gene cluster with 100% similarity. These results indicate that despite its relatively smaller genome, YNK-FS0020 exhibits a greater potential for secondary metabolism, i.e., it harbors more gene clusters involved in secondary metabolite biosynthesis, suggesting stronger environmental adaptability and a higher capacity for producing bioactive substances. This provides a significant theoretical basis for its application in agricultural biocontrol and plant growth promotion.
Streptomycetes, renowned for their robust capacity to produce bioactive compounds, have become one of the most studied microorganisms among prokaryotes, and they have been widely used in plant disease control in numerous studies. For instance, S. olivoreticuli ZZ-21 can effectively control tobacco target spot disease caused by Rhizoctonia solani [45]; S. sp. AGS-58 can efficiently inhibit the growth of Colletotrichum siamense on mango fruits [46]; S. atratus PY-1 can significantly reduce phytophthora blight caused by P. capsici [47]; S. sp. MBFA-172 [48] and H4 [49] can notably decrease the incidence of strawberry anthracnose; S. sp. JBS5-6 has strong inhibitory ability against spore germination and mycelial development of F. oxysporum f. sp. cubense TR4, the pathogen causing banana wilt [50]; and S. monashensis h114 effectively reduces the severity of citrus green mold [51]. Furthermore, Streptomycetes can produce a variety of secondary metabolites that have been applied in biopesticides, such as jinggangmycin [52] and avermectin [53]. In this study, S. olivoreticuli YNK-FS0020 was isolated from the rhizosphere soil of a forest in Dali, Yunnan Province. In vitro plate antagonism and non-volatile substance antifungal assays demonstrated that this strain shows good inhibitory activity against seven important soil-borne pathogens, with inhibition rates all exceeding 60%. These pathogens correspond to diseases including F. oxysporum f. sp. cubense TR4-induced banana wilt, F. solani root rot, F. graminearum-triggered wheat scab, F. equiseti-related root and stem diseases, P. capsici-associated pepper blight, P. parasitica-linked tobacco black shank, and R. necatrix fruit tree southern blight. Furthermore, this strain possesses the abilities to solubilize both organic and inorganic phosphorus, produce siderophores, and effectively promote plant growth, indicating its great application potential in plant growth promotion and biological control of soil-borne diseases.
Streptomycetes produce a diverse range of secondary metabolites through the biosynthesis of polyketides, nucleosides, peptides, and hydrolases, which can inhibit or even eliminate pathogens [54]. Additionally, Streptomycetes generate various bioactive compounds with antimicrobial properties, such as enzymes, organic acids, amino acids, immunomodulators, and vitamins [55,56,57]. A total of 47 potential biosynthetic gene clusters (BGCs) responsible for secondary metabolites were identified in the genome of strain YNK-FS0020. Among them, 12 gene clusters showed significant similarity (>60%) to known BGCs, and 4 gene clusters exhibited 100% similarity, corresponding to antimycin, antipain, geosmin, and ectoine. Antimycin compounds, a class of natural antibiotics produced by Streptomycetes, possess multiple biological activities, mainly including insecticidal, antifungal, antitumor, and anti-inflammatory effects [58]. Antipain is a novel antipain analog isolated from the fermentation broth of S. sp. MJ218-CF4; it acts as a protease inhibitor to suppress PAR signaling, thereby reducing the release of excitatory neuropeptides and inhibiting pain [59]. Ectoine, a natural compatible solute produced by halophilic microorganisms, has significant cytoprotective effects. It helps cells resist extreme environmental stresses (such as high salt, high temperature, low temperature, and desiccation) by stabilizing the structures of proteins, nucleic acids, and cell membranes [60]. Ectoine has been studied in the medical field for anti-inflammatory purposes, skin repair, and the treatment of respiratory diseases; in cosmetics, it functions as a moisturizer and antioxidant, capable of repairing UV damage and delaying skin aging; in biotechnology, it is used to enhance the stability of enzymes and cells, extending their active lifespan [61,62,63]. The identification of these gene clusters involved in the synthesis of bioactive compounds related to antimicrobial, insecticidal, and enzyme/cell stability-enhancing activities in the genome of strain YNK-FS0020 provides new insights into the disease-suppressive mechanism of this strain. Furthermore, many BGCs in strain YNK-FS0020 exhibit low similarity (<60%) to known ones, with 14 gene clusters showing less than 20% similarity and 5 gene clusters having no detectable similarity to known BGCs. This indicates that strain YNK-FS0020 carries numerous genes with potential novel functions, highlighting its significant research potential [54].
Beneficial bacterial strains promote plant growth through multiple pathways, with one core mechanism being the secretion of plant hormones (such as indole-3-acetic acid (IAA), cytokinins, and gibberellins) to directly stimulate plant growth and development [23]; for example, Serratia marcescens PLR promotes lateral root formation by secreting endogenously synthesized auxins and enhancing the biosynthesis of endogenous auxins in Arabidopsis thaliana [64]. As a direct precursor for IAA synthesis, the metabolic level of tryptophan directly regulates the efficiency of IAA synthesis [65]. In this study, the genome of strain YNK-FS0020 was annotated with 7 genes involved in tryptophan biosynthesis and 1 gene closely related to IAA synthesis. The bioavailability of phosphorus often restricts plant development; phosphate-solubilizing bacteria can improve the soil available phosphorus content by solubilizing insoluble phosphate or organic phosphorus compounds in soil, thereby indirectly promoting plant growth [23,66]. Previous studies have confirmed that Bacillus subtilis RS10 and Enterobacter roggenkampii ED5 can both solubilize soil phosphate and promote plant growth [67,68], while the genome of strain YNK-FS0020 was annotated with 13 genes related to phosphate transport, signal regulation, and metabolism. The synthesis and uptake of siderophores are important pathways for microorganisms to assist plants in acquiring iron and inhibiting pathogens, as siderophores can improve iron bioavailability by chelating environmental iron ions and inhibit pathogen growth by competing for iron sources, thereby maintaining plant health [69]. Five genes related to siderophore synthesis and 7 genes related to siderophore uptake were identified in the genome of strain YNK-FS0020. In addition, non-targeted metabolomics analysis further confirmed that the fermentation broth of strain YNK-FS0020 contains various functional metabolites, including kitasamycin and minocycline with antibacterial activity, indole-3-acetic acid that promotes plant growth, hydroquinone with antioxidant activity, and staurosporine with potential antitumor activity. In summary, strain YNK-FS0020 has comprehensive potential in terms of promoting plant growth and maintaining plant health through multiple mechanisms such as the tryptophan-IAA synthesis pathway, phosphorus-solubilizing metabolism, siderophore-mediated iron nutrient supply, and secretion of antibacterial substances, providing a theoretical basis for its application in agricultural production.
In summary, the results of this study indicate that strain YNK-FS0020 exhibits significant in vitro inhibitory activity against various soil-borne pathogens and harbors potential plant growth-promoting traits such as IAA production, phosphate solubilization, and siderophore production. Additionally, the fermentation broth of this strain contains multiple functional metabolites including indole-3-acetic acid and kitasamycin. These characteristics collectively demonstrate that the strain has potential application value in the biological control of soil-borne diseases. However, current research still has several important limitations. Firstly, key functional parameters such as IAA production, phosphate solubilization efficiency, and siderophore production capacity have not yet been quantitatively characterized. Secondly, there is a lack of in vivo validation data from plant inoculation experiments to evaluate its actual control efficacy. The lack of such critical data constrains the accurate assessment of the strain’s application potential.
5. Conclusions
Strain YNK-FS0020, isolated from the rhizosphere soil of Wuliang Mountain forest in Dali, was identified as S. olivoreticuli through whole-genome sequencing. This strain not only exhibits strong antagonistic activity against various plant pathogens but also possesses comprehensive biological activities such as phosphorus solubilization (both organic and inorganic phosphorus), siderophore production, and plant growth promotion, demonstrating broad application potential in the biological control of plant diseases and crop growth promotion. Genomic analysis revealed that it contains 47 secondary metabolite biosynthetic gene clusters (BGCs), including those with known functions such as antimycin and ectoine, as well as a large number of BGCs with low similarity or unknown functions, confirming its abundant secondary metabolic potential. At the mechanistic level, the strain exerts a synergistic effect through multiple pathways. In summary, YNK-FS0020 is a multifunctional microbial resource with both application value and research prospects. Its genomic and metabolomic data provide a molecular basis for elucidating biological functions. In the future, heterologous expression, gene editing, and other technologies could be used to further explore the synthesis mechanism of active substances, promoting its industrial application.
Supplementary Materials
The following supporting information can be downloaded at: https://www.mdpi.com/article/10.3390/microorganisms13091964/s1, Supplementary Excel S1: Compound annotation table for non-targeted metabolomics of YNK-FS0020 fermentation broth; Figure S1: Known secondary metabolite biosynthetic gene clusters (with 100% similarity) in the genome of strain YNK-FS0020 predicted by antiSMASH; Figure S2: Tryptophan biosynthesis pathway of strain YNK-FS0020; Table S1: Physiological and biochemical characteristics of strain YNK-FS0020; Table S2: ANI and dDDH values between the genome of strain YNK-FS0020 and reference genomes of the genus Streptomyces; Table S3: Genomic comparison among S. olivoreticuli YNK-FS0020, S. olivoreticuli ZZ-21, S. albireticuli MDJK11, S. griseus NBC-01630, and S. venezuelae ATCC-10712.
Author Contributions
Conceptualization, X.L., Y.L., Z.S. (Zhufeng Shi), T.P., Z.S. (Zhuli Shi), J.J., Y.W., F.H. and P.Y.; methodology, P.Y.; software, Y.L.; formal analysis, X.L.; investigation, Z.S. (Zhufeng Shi), T.P. and J.J.; resources, Z.S. (Zhuli Shi), Y.W. and F.H.; writing—original draft, X.L.; writing—review and editing, X.L. and P.Y.; funding acquisition, P.Y. All authors have read and agreed to the published version of the manuscript.
Funding
This research was supported by the Yunnan Provincial Science and Technology Plan Project (202202AE090010), the Central Government Guided Local Science and Technology Development Fund (202407AC110006), and the Yunnan Province “Xingdian Talent” Support Program (XDYC-CYCX-2002-0071).
Institutional Review Board Statement
Not applicable.
Informed Consent Statement
Not applicable.
Data Availability Statement
Genome sequences were deposited in the GenBank database under accession number JBMYHM000000000 (https://www.ncbi.nlm.nih.gov/nuccore/JBMYHM000000000.1/, accessed on 16 March 2025).
Conflicts of Interest
The authors declare no conflicts of interest.
References
- Niu, B.; Wang, W.; Yuan, Z.; Sederoff, R.; Sederoff, H.; Chiang, V.; Borriss, R. Microbial interactions within multiple-strain biological control agents impact soil-borne plant disease. Front. Microbiol. 2020, 11, 585404. [Google Scholar] [CrossRef]
- Fang, X.; Zhang, C.; Wang, Z.; Duan, T.; Yu, B.; Jia, X.; Pang, J.; Ma, L.; Wang, Y.; Nan, Z. Co-infection by soil-borne fungal pathogens alters disease responses among diverse alfalfa varieties. Front. Microbiol. 2021, 12, 664385. [Google Scholar] [CrossRef] [PubMed]
- Wang, Z.; Gao, C.; Yang, J.; Du, R.; Zeng, F.; Bing, H.; Xia, B.; Shen, Y.; Liu, C. Endophytic Streptomyces sp. NEAU-ZSY13 from the leaf of Perilla frutescens, as a promising broad-spectrum biocontrol agent against soil-borne diseases. Front. Microbiol. 2023, 14, 1243610. [Google Scholar] [CrossRef]
- Wei, J.; Zhao, J.; Suo, M.; Wu, H.; Zhao, M.; Yang, H. Biocontrol mechanisms of Bacillus velezensis against Fusarium oxysporum from Panax ginseng. Biol. Control 2023, 182, 105222. [Google Scholar] [CrossRef]
- Zhang, H.; Godana, E.; Sui, Y.; Yang, Q.; Zhang, X.; Zhao, L. Biological control as an alternative to synthetic fungicides for the management of grey and blue mould diseases of table grapes: A review. Crit. Rev. Microbiol. 2020, 46, 450–462. [Google Scholar] [CrossRef]
- Tao, C.; Li, R.; Xiong, W.; Shen, Z.; Liu, S.; Wang, B.; Ruan, Y.; Geisen, S.; Shen, Q.; Kowalchuk, G. Bio-organic fertilizers stimulate indigenous soil Pseudomonas populations to enhance plant disease suppression. Microbiome 2020, 8, 137. [Google Scholar] [CrossRef]
- Wei, D.; Zhu, D.; Zhang, Y.; Yang, Z.; Wu, X.; Shang, J.; Yang, W.; Chang, X. Characterization of rhizosphere Pseudomonas chlororaphis IRHB3 in the reduction of Fusarium root rot and promotion of soybean growth. Biol. Control 2023, 186, 105349. [Google Scholar] [CrossRef]
- Erazo, J.; Palacios, S.; Pastor, N.; Giordano, F.; Rovera, M.; Reynoso, M.; Venisse, J.; Torres, A. Biocontrol mechanisms of Trichoderma harzianum ITEM 3636 against peanut brown root rot caused by Fusarium solani RC 386. Biol. Control 2021, 164, 104774. [Google Scholar] [CrossRef]
- Ta, Y.; Fu, S.; Liu, H.; Zhang, C.; He, M.; Yu, H.; Ren, Y.; Han, Y.; Hu, W.; Yan, Z.; et al. Evaluation of Bacillus velezensis F9 for cucumber growth promotion and suppression of Fusarium wilt disease. Microorganisms 2024, 12, 1882. [Google Scholar] [CrossRef]
- Jose, P.; Maharshi, A.; Jha, B. Actinobacteria in natural products research: Progress and prospects. Microbiol. Res. 2021, 246, 126708. [Google Scholar] [CrossRef]
- Mitchell, W. Natural products from synthetic biology. Curr. Opin. Chem. Biol. 2011, 15, 505–515. [Google Scholar] [CrossRef] [PubMed]
- Gillon, A.; Abdelrahman, O.; Abou-Mansour, E.; L’Haridon, F.; Falquet, L.; Allard, P.; Weisskopf, L. Comparative genomic and metabolomic study of three Streptomyces sp. differing in biological activity. Microbiologyopen 2023, 12, e1389. [Google Scholar] [CrossRef]
- Zhang, Q.; Qian, S. Progress in research on alkaloids and pharmacological activities from Streptomyces. Nat. Prod. Res. Dev. 2019, 31, 1461–1473. [Google Scholar]
- Wei, M.; Jiao, M.; Nie, X.; Wang, C.; Yu, X.; Liu, Y.; Wei, X. Genomic and metabolomic profiling reveal Streptomyces rochei S32 contributes to plant growth by nitrogen fixation and production of bioactive substances. Plant Soil 2024, 501, 343–360. [Google Scholar] [CrossRef]
- Mascher, T.; Margulis, N.; Wang, T.; Ye, R.; Helmann, J. Cell wall stress responses in Bacillus subtilis: The regulatory network of the bacitracin stimulon. Mol. Microbiol. 2003, 50, 1591–1604. [Google Scholar] [CrossRef] [PubMed]
- Siewert, G.; Strominger, J. Bacitracin: An inhibitor of the dephosphorylation of lipid pyrophosphate, an intermediate in the biosynthesis of the peptidoglycan of bacterial cell walls. Proc. Natl. Acad. Sci. USA 1967, 57, 767–773. [Google Scholar] [CrossRef] [PubMed]
- Zhang, Z.; Zhou, Y.; Zhang, H.; Du, X.; Cao, Z.; Wu, Y.; Liu, C.; Sun, Y. Antibacterial activity and mechanisms of troHepc2-22, a derived peptide of hepcidin2 from golden pompano (Trachinotus ovatus). Int. J. Mol. Sci. 2023, 24, 9251. [Google Scholar] [CrossRef]
- De la Cruz-Rodríguez, Y.; Adrián-López, J.; Martínez-López, J.; Neri-Márquez, B.; García-Pineda, E.; Alvarado-Gutiérrez, A.; Fraire-Velázquez, S. Biosynthetic gene clusters in sequenced genomes of four contrasting rhizobacteria in phytopathogen inhibition and interaction with Capsicum annuum roots. Microbiol. Spectr. 2023, 11, e0307222. [Google Scholar] [CrossRef] [PubMed]
- Nakamura, T. Inhibition of several antibotics on D-amino acid oxidase. J. Vitaminol. 1959, 5, 277–286. [Google Scholar] [CrossRef]
- Shi, L.; Nwet, T.; Ge, B.; Zhao, W.; Liu, B.; Cui, H.; Zhang, K. Antifungal and plant growth-promoting activities of Streptomyces roseoflavus strain NKZ-259. Biol. Control 2018, 125, 57–64. [Google Scholar] [CrossRef]
- Dong, X.; Zhou, Y.; Zhu, H. Manual for Systematic Classification and Identification of Common Bacteria and Archaea, 1st ed.; Science Press: Beijing, China, 2023; pp. 510–544. [Google Scholar]
- Xu, W.; Liu, Y.; Cheng, Y.; Zhang, J. Plant growth-promoting effect and complete genomic sequence analysis of the beneficial rhizosphere Streptomyces sp. GD-4 isolated from Leymus secalinus. Microorganisms 2025, 13, 286. [Google Scholar] [CrossRef]
- Wang, Y.; Sun, Z.; Zhao, Q.; Yang, X.; Li, Y.; Zhou, H.; Zhao, M.; Zheng, H. Whole-genome analysis revealed the growth-promoting and biological control mechanism of the endophytic bacterial strain Bacillus halotolerans Q2H2, with strong antagonistic activity in potato plants. Front. Microbiol. 2024, 14, 1287921. [Google Scholar] [CrossRef]
- Singh, R.; Singh, P.; Li, H.; Guo, D.; Song, Q.; Yang, L.; Malviya, M.; Song, X.; Li, Y. Plant-PGPR interaction study of plant growth-promoting diazotrophs Kosakonia radicincitans BA1 and Stenotrophomonas maltophilia COA2 to enhance growth and stress-related gene expression in Saccharum spp. J. Plant Interact. 2020, 15, 427–445. [Google Scholar] [CrossRef]
- Gao, M.; Zhou, J.; Wang, E.; Chen, Q.; Xu, J.; Sun, J. Multiphasic characterization of a plant growth promoting bacterial strain, Burkholderia sp. 7016 and its effect on tomato growth in the field. J. Integr. Agric. 2015, 14, 1855–1863. [Google Scholar] [CrossRef]
- Schwyn, B.; Neilands, J. Universal chemical assay for the detection and determination of siderophores. Anal. Biochem. 1987, 160, 47–56. [Google Scholar] [CrossRef]
- Blin, K.; Shaw, S.; Augustijn, H.; Reitz, Z.; Biermann, F.; Alanjary, M.; Fetter, A.; Terlouw, B.; Metcalf, W.; Helfrich, E.; et al. antiSMASH 7.0: New and improved predictions for detection, regulation, chemical structures and visualisation. Nucleic Acids Res. 2023, 51, W46–W50. [Google Scholar] [CrossRef]
- Alikhan, N.; Petty, N.; Ben Zakour, N.; Beatson, S. BLAST Ring Image Generator (BRIG): Simple prokaryote genome comparisons. BMC Genom. 2011, 12, 402. [Google Scholar] [CrossRef] [PubMed]
- Sun, J.; Lu, F.; Luo, Y.; Bie, L.; Xu, L.; Wang, Y. OrthoVenn3: An integrated platform for exploring and visualizing orthologous data across genomes. Nucleic Acids Res. 2023, 51, W397–W403. [Google Scholar] [CrossRef]
- Liang, X.; Ishfaq, S.; Liu, Y.; Jijakli, M.; Zhou, X.; Yang, X.; Guo, W. Identification and genomic insights into a strain of Bacillus velezensis with phytopathogen-inhibiting and plant growth-promoting properties. Microbiol. Res. 2024, 285, 127745. [Google Scholar] [CrossRef] [PubMed]
- Zhang, H.; Xie, Z.; Lou, T.; Wang, S. Complete genome sequence of Streptomyces olivoreticuli ATCC 31159 which can produce anticancer bestatin and show diverse secondary metabolic potentials. Curr. Microbiol. 2019, 76, 370–375. [Google Scholar] [CrossRef] [PubMed]
- Liu, C.; Li, J.; Guo, Y. Whole genome sequencing and antibacterial activity determination of two novel species of Microbispora. Microbiol. China 2021, 48, 1662–1673. [Google Scholar]
- Naughton, L.; Romano, S.; O’Gara, F.; Dobson, A. Identification of secondary metabolite gene clusters in the Pseudovibrio genus reveals encouraging biosynthetic potential toward the production of novel bioactive compounds. Front. Microbiol. 2017, 8, 1494. [Google Scholar] [CrossRef]
- Ibrahim, Y.; Abouwarda, A.; Omar, F. Effect of kitasamycin and nitrofurantoin at subinhibitory concentrations on quorum sensing regulated traits of Chromobacterium violaceum. Antonie Leeuwenhoek 2020, 113, 1601–1615. [Google Scholar] [CrossRef] [PubMed]
- Singh, S.; Khanna, D.; Kalra, S. Minocycline and doxycycline: More than antibiotics. Curr. Mol. Pharmacol. 2021, 14, 1046–1065. [Google Scholar] [CrossRef]
- Liao, J.; Qi, Q.; Kuang, L.; Zhou, Y.; Xiao, Q.; Liu, T.; Wang, X.; Guo, L.; Jiang, Y. Chloramphenicol binding sites of Acinetobacter baumannii chloramphenicol acetyltransferase CatB8. ACS Infect. Dis. 2024, 10, 870–878. [Google Scholar] [CrossRef]
- Zeng, H.; He, K.; He, Q.; Xu, L.; Zhang, W.; Lu, X.; Tang, Y.; Zhu, X.; Yin, J.; He, M.; et al. Exogenous indole-3-acetic acid suppresses rice infection of Magnaporthe oryzae by affecting plant resistance and fungal growth. Phytopathology 2024, 114, 1050–1056. [Google Scholar] [CrossRef] [PubMed]
- Traxler, M.; Seyedsayamdost, M.; Clardy, J.; Kolter, R. Interspecies modulation of bacterial development through iron competition and siderophore piracy. Mol. Microbiol. 2012, 86, 628–644. [Google Scholar] [CrossRef]
- Park, Y.; Kim, J.; Yun, C. Identification of ferrichrome- and ferrioxamine B-mediated iron uptake by Aspergillus fumigatus. Biochem. J. 2016, 473, 1203–1213. [Google Scholar] [CrossRef]
- Tziveleka, L.; Kourounakis, A.; Kourounakis, P.; Roussis, V.; Vagias, C. Antioxidant potential of natural and synthesised polyprenylated hydroquinones. Bioorg. Med. Chem. 2002, 10, 935–939. [Google Scholar] [CrossRef]
- Gescher, A. Staurosporine analogues-pharmacological toys or useful antitumour agents? Crit. Rev. Oncol./Hematol. 2000, 34, 127–135. [Google Scholar] [CrossRef]
- Li, Y.; Li, K.; Zhao, Y.; Li, Y.; Li, D.; Shen, L.; Wang, Q.; Yang, H.; Sun, Z. Emodin-8-O-β-D-glucopyranoside, a natural hydroxyanthraquinone glycoside from plant, suppresses cancer cell proliferation via p21-CDKs-Rb axis. Toxicol. Appl. Pharmacol. 2022, 438, 115909. [Google Scholar] [CrossRef] [PubMed]
- Mao, Y.; Varoglu, M.; Sherman, D. Genetic localization and molecular characterization of two key genes (mitAB) required for biosynthesis of the antitumor antibiotic mitomycin C. J. Bacteriol. 1999, 181, 2199–2208. [Google Scholar] [CrossRef] [PubMed]
- Douka, D.; Spantidos, T.; Tsalgatidou, P.; Katinakis, P.; Venieraki, A. Whole-genome profiling of endophytic strain B.L.Ns.14 from Nigella sativa reveals potential for agricultural bioenhancement. Microorganisms 2024, 12, 2604. [Google Scholar] [CrossRef] [PubMed]
- Zhong, J.; Sui, W.; Bai, X.; Qiu, Z.; Li, X.; Zhu, J. Characterization and biocontrol mechanism of Streptomyces olivoreticuli as a potential biocontrol agent against Rhizoctonia solani. Pestic. Biochem. Physiol. 2023, 197, 105681. [Google Scholar] [CrossRef]
- Evangelista-Martínez, Z.; Ek-Cen, A.; Torres-Calzada, C.; Uc-Várguez, A. Potential of Streptomyces sp. strain AGS-58 in controlling anthracnose-causing Colletotrichum siamense from post-harvest mango fruits. J. Plant Pathol. 2022, 104, 553–563. [Google Scholar] [CrossRef]
- Zang, C.; Kong, T.; Liang, B.; Liu, X.; Xie, J.; Lin, Y.; Pei, X.; Yu, S.; Liang, C. Evaluation of imide substance from Streptomyces atratus PY-1 for the biocontrol of phytophthora blight. Eur. J. Plant Pathol. 2023, 165, 725–734. [Google Scholar] [CrossRef]
- Marian, M.; Ohno, T.; Suzuki, H.; Kitamura, H.; Kuroda, K.; Shimizu, M. A novel strain of endophytic Streptomyces for the biocontrol of strawberry anthracnose caused by Glomerella cingulata. Microbiol. Res. 2020, 234, 126428. [Google Scholar] [CrossRef]
- Li, X.; Jing, T.; Zhou, D.; Zhang, M.; Qi, D.; Zang, X.; Zhao, Y.; Li, K.; Tang, W.; Chen, Y.; et al. Biocontrol efficacy and possible mechanism of Streptomyces sp. H4 against postharvest anthracnose caused by Colletotrichum fragariae on strawberry fruit. Postharvest Biol. Technol. 2021, 175, 111401. [Google Scholar] [CrossRef]
- Jing, T.; Zhou, D.; Zhang, M.; Yun, T.; Qi, D.; Wei, Y.; Chen, Y.; Zang, X.; Wang, W.; Xie, J. Newly isolated Streptomyces sp. JBS5-6 as a potential biocontrol agent to control banana fusarium wilt: Genome sequencing and secondary metabolite cluster profiles. Front. Microbiol. 2020, 11, 602591. [Google Scholar] [CrossRef]
- Tian, Z.; Du, Y.; Lu, Y.; Zhu, J.; Long, C. Exploration of the antimicrobial activities of biocontrol agent Streptomyces strain h114 against Penicillium digitatum in citrus. Postharvest Biol. Technol. 2024, 210, 112725. [Google Scholar] [CrossRef]
- Dong, W.; Wu, W.; Song, C.; Li, T.; Zhang, J. Jinggangmycin stimulates reproduction and increases CHCs-dependent desiccation tolerance in Drosophila melanogaster. Pestic. Biochem. Physiol. 2023, 194, 105484. [Google Scholar] [CrossRef]
- Li, M.; Chen, Z.; Zhang, X.; Song, Y.; Wen, Y.; Li, J. Enhancement of avermectin and ivermectin production by overexpression of the maltose ATP-binding cassette transporter in Streptomyces avermitilis. Bioresour. Technol. 2010, 101, 9228–9235. [Google Scholar] [CrossRef]
- Xu, G.; Wu, W.; Zhu, L.; Liang, Y.; Liang, M.; Tan, S.; Chen, H.; Huang, X.; He, C.; Lu, Y.; et al. Whole Genome sequencing and biocontrol potential of Streptomyces luteireticuli ASG80 against Phytophthora diseases. Microorganisms 2024, 12, 2255. [Google Scholar] [CrossRef] [PubMed]
- Sharma, V.; Kaur, R.; Salwan, R. Streptomyces: Host for refactoring of diverse bioactive secondary metabolites. 3 Biotech 2021, 11, 340. [Google Scholar] [CrossRef]
- Barbuto Ferraiuolo, S.; Cammarota, M.; Schiraldi, C.; Restaino, O. Streptomycetes as platform for biotechnological production processes of drugs. Appl. Microbiol. Biotechnol. 2021, 105, 551–568. [Google Scholar] [CrossRef] [PubMed]
- Lacey, H.; Rutledge, P. Recently discovered secondary metabolites from Streptomyces species. Molecules 2022, 27, 887. [Google Scholar] [CrossRef] [PubMed]
- Tan, H.; Che, Q.; Li, D.; Gu, Q.; Zhu, T. Progress in the research of antimycin-type compounds. Chin. J. Antibiot. 2015, 40, 892–900. [Google Scholar]
- Nakae, K.; Kojima, F.; Sawa, R.; Kubota, Y.; Igarashi, M.; Kinoshita, N.; Adachi, H.; Nishimura, Y.; Akamatsu, Y. Antipain Y, a new antipain analog that inhibits neurotransmitter release from rat dorsal root ganglion neurons. J. Antibiot. 2010, 63, 41–44. [Google Scholar] [CrossRef][Green Version]
- Song, Q.; Sun, L.; Yin, Y.; Xia, C.; Xin, J. Bioprotection effect of ectoine and its application in food field. China Condiment 2024, 49, 213–220. [Google Scholar]
- Liu, M.; Liu, H.; Shi, M.; Jiang, M.; Li, L.; Zheng, Y. Microbial production of ectoine and hydroxyectoine as high-value chemicals. Microb. Cell Factories 2021, 20, 76. [Google Scholar] [CrossRef]
- Chen, J.; Qiao, D.; Yuan, T.; Feng, Y.; Zhang, P.; Wang, X.; Zhang, L. Biotechnological production of ectoine: Current status and prospects. Folia Microbiol. 2024, 69, 247–258. [Google Scholar] [CrossRef] [PubMed]
- Pastor, J.; Salvador, M.; Argandoña, M.; Bernal, V.; Reina-Bueno, M.; Csonka, L.; Iborra, J.; Vargas, C.; Nieto, J.; Cánovas, M. Ectoines in cell stress protection: Uses and biotechnological production. Biotechnol. Adv. 2010, 28, 782–801. [Google Scholar] [CrossRef] [PubMed]
- Zhang, C.; Yu, Z.; Zhang, M.; Li, X.; Wang, M.; Li, L.; Li, X.; Ding, Z.; Tian, H. Serratia marcescens PLR enhances lateral root formation through supplying PLR-derived auxin and enhancing auxin biosynthesis in Arabidopsis. J. Exp. Bot. 2022, 73, 3711–3725. [Google Scholar] [CrossRef]
- Zaidi, A.; Khan, M.; Ahemad, M.; Oves, M. Plant growth promotion by phosphate solubilizing bacteria. Acta Microbiol. Immunol. Hung. 2009, 56, 263–284. [Google Scholar] [CrossRef]
- Huang, X.; Zeng, Z.; Chen, Z.; Tong, X.; Jiang, J.; He, C.; Xiang, T. Deciphering the potential of a plant growth promoting endophyte Rhizobium sp. WYJ-E13, and functional annotation of the genes involved in the metabolic pathway. Front. Microbiol. 2022, 13, 1035167. [Google Scholar] [CrossRef]
- Iqbal, S.; Ullah, N.; Janjua, H. In Vitro evaluation and genome mining of Bacillus subtilis strain RS10 reveals its biocontrol and plant growth-promoting potential. Agriculture 2021, 11, 1273. [Google Scholar] [CrossRef]
- Guo, D.; Singh, R.; Singh, P.; Li, D.; Sharma, A.; Xing, Y.; Song, X.; Yang, L.; Li, Y. Complete genome sequence of Enterobacter roggenkampii ED5, a nitrogen fixing plant growth promoting endophytic bacterium with biocontrol and stress tolerance properties, isolated from sugarcane root. Front. Microbiol. 2020, 11, 580081. [Google Scholar] [CrossRef] [PubMed]
- Kumar, P.; Rani, S.; Dahiya, P.; Kumar, A.; Dang, A.; Suneja, P. Whole genome analysis for plant growth promotion profiling of Pantoea agglomerans CPHN2, a non-rhizobial nodule endophyte. Front. Microbiol. 2022, 13, 998821. [Google Scholar] [CrossRef] [PubMed]
Disclaimer/Publisher’s Note: The statements, opinions and data contained in all publications are solely those of the individual author(s) and contributor(s) and not of MDPI and/or the editor(s). MDPI and/or the editor(s) disclaim responsibility for any injury to people or property resulting from any ideas, methods, instructions or products referred to in the content. |
© 2025 by the authors. Licensee MDPI, Basel, Switzerland. This article is an open access article distributed under the terms and conditions of the Creative Commons Attribution (CC BY) license (https://creativecommons.org/licenses/by/4.0/).












